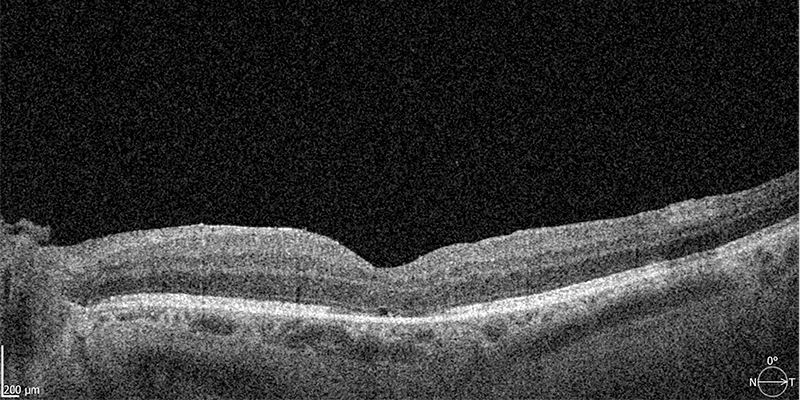

Makulaloch (Makulaforamen)
Die Makula liegt im zentralen Bereich der Netzhaut und hat einen Durchmesser von 3 bis 5 mm. In der Mitte der Makula erreichen die farbempfindlichen Sinneszellen (die Zapfen) die größte Dichte, daher ist dieser Bereich auch die Stelle des schärfsten Sehens.
Ein Loch in der Makula, das sogenannte Makulaforamen, führt zum Ausfall des zentralen Sehens. Die Sehverschlechterung entwickelt sich meist langsam über viele Wochen. Betroffene nehmen in der Bildmitte einen grauen Fleck wahr, der mit Zunahme des Makulalochs größer wird. Daneben kann es gelegentlich auch zu einem „verzerrten“ Sehen kommen. Bleibt das Makulaloch länger bestehen, kann sich auch die umgebende Netzhaut ablösen und so zu einer weiteren Sehverminderung führen.
Diagnose
Ähnliche Beschwerden zeigen sich auch bei anderen Netzhaut-, bzw. Makulaerkrankungen, wie der epiretinalen Gliose oder der Altersbedingten Makuladegeneration (AMD). So ist zur Diagnose des Makulaforamens die eingehende augenärztliche Untersuchung erforderlich.
Die Ursachen für ein Makulaloch sind bislang nicht im Detail bekannt. Meist handelt es sich jedoch um altersbedingte Veränderungen im Grenzbereich zwischen dem Glaskörper und der darunterliegenden Netzhaut. Dabei können Zugkräfte auf die Makula ausgeübt werden und so zu einem Makulaloch führen. Betroffen sind meist Patienten ab dem 60. Lebensjahr.
Zur Diagnose eines Makulalochs führen wir zunächst einen Sehtest durch und untersuchen dann mit der Spaltlampe und vergrößernden Lupen die Oberfläche der Netzhaut.
Mit der hochauflösenden optischen Kohärenztomographie (OCT) können wir die verschiedenen Netzhautschichten detailreich im Querschnitt sichtbar machen und das Makulaloch exakt darstellen. Auch die Größe des Makulalochs kann so ermittelt werden.
Diese Untersuchung dauert nur wenige Sekunden und erfolgt ohne Berührung des Auges.

Optische Kohärenztomographie (OCT) – Vor der OP: Das Makulaloch ist deutlich zu erkennen (Pfeil)
Nach der OP: Das Loch ist verschlossen und die Sehschärfe deutlich verbessert
Behandlung
Ein Makulaloch kann nur mit einer Operation behandelt werden. Bei diesem mikrochirurgischen Eingriff werden mit feinsten Instrumenten der Glaskörper und auch vorhandene Membranen (Häutchen), die zum Makulaloch führen, entfernt. Durch Beseitigung der Zugkräfte auf die Makula, kann sich das Loch wieder verschließen. Zur Stabilisierung wird anschließend ein Gasgemisch in das Augeninnere eingegeben. Das Gasgemisch löst sich in den folgenden Wochen auf und wird durch das körpereigene Augenwasser ersetzt, das sich fortlaufend neu bildet.
Dieser mikrochirurgische Eingriff ist mit der heute zur Verfügung stehenden Operationstechnik sehr sicher und kann in örtlicher Betäubung durchgeführt werden.
Heilungsverlauf
Der Heilungsverlauf benötigt einen längeren Zeitraum von mehreren Wochen oder Monaten. In diesem Zeitraum verbessert sich Ihr Sehvermögen kontinuierlich. Insbesondere bei einer frühzeitigen Operation kann es möglich sein, die Sehkraft wieder vollständig herzustellen. Auch wenn ein Makulaloch schon seit längerer Zeit besteht und sich das Sehen bereits sehr verschlechtert hat, kann die Operation eine deutliche Verbesserung bewirken. Den Heilungsverlauf können wir mit der optischen Kohärenztomographie sehr genau kontrollieren.
Gut zu wissen:
Ein Makulaloch können wir mit modernsten und hochauflösenden Medizingeräten sicher diagnostizieren.
Die minimal-invasive mikrochirurgische Behandlung wird ambulant in unserem operativen Zentrum durchgeführt. So können wir in den allermeisten Fällen eine deutliche Verbesserung des Sehvermögens herstellen.
Individuelle Beratung in unserer Netzhautsprechstunde
Wir beantworten gerne Ihre Fragen zum Makulaforamen und informieren Sie über den Behandlungsablauf.